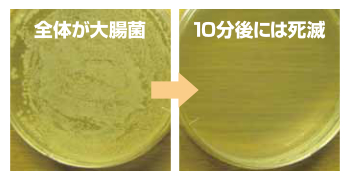
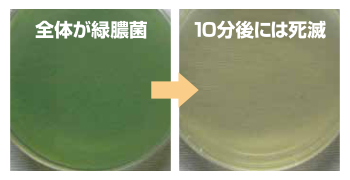

ウィルデリート 水溶液 商品説明
天然抗菌剤でウイルス対策
- ワンプッシュで洗浄
- 天然抗菌剤を使用
- ノンアルコールタイプ
食品にも使用されている、口に入っても安全な成分
天然抗菌剤
厳選したホタテ貝殻を焼成炉で約1000℃の高温で焼成し加水をすることにより水酸化カルシウムに変化します。粉砕の工程を経て微粉末化をしたパウダーは、環境にも優しい高性能で安全な「天然抗菌剤」です。
アルコール、次亜塩素酸、界面活性剤を未使用の新しいタイプの衛生用品です。主成分は超微細水と天然抗菌剤で生成した水溶液はアルカリ性pH12.5以上の数値を示し、そのアルカリのパワーがウイルスを予防する安全安心な感染予防水溶液です。化学薬品が未使用なので、使用法は洗い流す必要がなく、ウイルスを抑制します。※水酸化カルシウムは厚生労働省の食品添加物に認可されており、安全安心な素材です。
大きな特徴
アルコール除菌は、問題視されているウイルスや細菌類の奉仕には効果が弱いと言われています。天然抗菌剤使用の「ウィルデリート」はノンアルコールでもウイルスが生息できないアルカリ領域で感染抑制・感染予防。
菌・ウイルスが生息できない水溶液
「ウィルデリート」はお出かけ前や帰宅後のご使用を。また詰め替え用はポンプ式だけでなく、市販のミニ容器に詰め替えて携帯し、お出かけ先でのご使用にも最適です。キッチンや玄関にはポンプタイプ。使い切ったら詰め替え用を入れ直してご使用いただけます。また公共施設などの不特定多数が利用される場所の出入り口やトイレ、エレベーターやエスカレーター乗り場での設置にお使いいただけます。
天然抗菌剤を生成した水溶液で感染しない、させない
感染しない、させない。自分を守り家族を守る。衛生マナーが大切です。
使用箇所の一例
公共の施設・乗り物・工場・店舗・ご家族にと活用いただいております。
- 病院
- 学校
- 幼稚園
- 託児所
- 福祉施設
- 介護施設
- 学習塾
- 車内
- 船内
- 飛行機内
- 空港内
- 電車駅
- 会社内
- 店舗内
- ペット店
- 食品工場
- 公共施設
- スーパー
- モール
- 飲食店
- ホテル
- 娯楽施設
- 遊戯施設
- ご家庭内
検証 効果例
細菌に対する除菌効果試験
試験(ウィルデリート)品を試験管に0.9ml分取
試験菌液0.1mlを摂取しボルテックスミキサーで攪拌、試料液とする
所定時間は5分とする 試料液の菌数測定

ネココロナウイルス

菌類を除菌することを実証済み
上記写真で大腸菌と緑膿菌をウィルデリートが菌を死滅させた事を実証しています。除菌効果試験結果からウィルデリートはノンアルコールでありながらも高い除菌の効果があることが分かります。
ネココロナウイルス減少率99.4%
昨今行ったネココロナウイルスの試験において1分で「減少率99.4%」という優秀な結果で、ウィルデリートが不活性化を実証していることが分かります。
ご使用上の注意
- ウイルス予防や対策以外にご使用ならないでください
- 傷や異常が現れた場合使用を中止し、専門医にご相談ください
- 小児の手の届かない所にて保管して下さい
- 高温や低温、直射日光のあたる場所で保管しないでください
- 目に入った時は直ちに洗い流してください
- ポンプが使用にともない固着する場合があります
- なるべく早く使い切ってください
- 容器底にカルシウム成分が結晶化して粉状に溜まる場合がございますが、使用上に問題はございません
- すべての菌・ウイルスを抑制・予防ができる訳ではございませんので予めご了承ください

